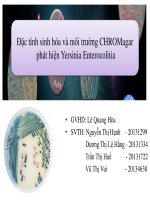
Đặc tính sinh hóa và môi trường CHROMagar phát hiện yersinia enterocolitia

Ảnh hưởng thời gian kích thích hormone lên đặc tính sinh hóa của dịch tương cá chẽm mõm nhọn Psammoperca waigiensis
Bạn đang xem bản rút gọn của tài liệu. Xem và tải ngay bản đầy đủ của tài liệu tại đây (502.64 KB, 9 trang )
Tạp chí Khoa học - Cơng nghệ Thủy sản
Số 4/2020
ẢNH HƯỞNG THỜI GIAN KÍCH THÍCH HORMONE LÊN ĐẶC TÍNH SINH
HĨA CỦA DỊCH TƯƠNG CÁ CHẼM MÕM NHỌN Psammoperca waigiensis
EFFECTS OF TIME AFTER HORMONAL STIMULATION ON BIOCHEMICAL FEATURES
OF SEMINAL PLASMA IN WAIGIEU SEAPERCH Psammoperca waigiensis
Lê Minh Hoàng, Nguyễn Văn Minh,
Phạm Quốc Hùng và Ngô Văn Mạnh
Viện Nuôi trồng thủy sản, Đại học Nha Trang
Tác giả liên hệ: Lê Minh Hoàng (Email: )
Ngày nhận bài: 01/11/2020; Ngày phản biện thông qua: 17/11/2020; Ngày duyệt đăng: 24/12/2020
TÓM TẮT:
Mục tiêu của nghiên cứu này nhằm đánh giá ảnh hưởng của thời gian kích thích hormone với
domperidone (DOM), luteinizing hormone releasing hormone analog (LHRHa) và human chorionic
gonadotropin (HCG) lên đặc tính sinh hóa của dịch tương cá chẽm mõm nhọn Psammoperca waigiensis
sau thời gian tiêm 72h. Cá đực được tiêm ở gốc vây bụng với 0.9% nước muối sinh lý (đối chứng) hoặc
tiêm một liều đơn DOM (20 mg/kg khối lượng cá (KL)) hoặc LHRHa (20, 50, hoặc 80 µg/kg KL) hoặc
HCG (500, 1000, hoặc 1500 IU/kg KL). Tinh dịch được thu trước khi tiêm hormone (0 h) để đánh giá đặc
tính sinh hóa dịch tương đầu tiên và thu tại thời điểm sau 24 h, 48 h, và 72 h sau khi tiêm hormone để
đánh giá ảnh hưởng của hormone lên đặc tính sinh hóa của dịch tương. Kết quả thí nghiệm của nghiên
cứu này cho thấy rằng việc tiêm kích thích hormone như được trình bày ở trên làm thay đổi hàm lượng
ion Na+ nhưng các đặc tính hóa sinh cịn lại của dịch tương thay đổi khơng đáng kể. Như vậy có thể kết
luận rằng việc tiêm hormone kích thích lên cá đực trong nghiên cứu này làm đặc tính sinh hóa thay đổi
khơng đáng kể.
Từ khóa: Cá chẽm mõm nhọn, kích thích hormone, đặc tính sinh hóa, LHRHa, HCG, DOM
ABSTRACT:
The objective of the present study was to assess the effects of time after stimulation with
domperidone (DOM), luteinizing hormone releasing hormone analog (LHRHa) and human chorionic
gonadotropin (HCG) on biochemical features of seminal plasma in Waigieu seaperch Psammoperca
waigiensis over period 72h post injection. Male broodfishes were injected pectoral fin corner with
either 0.9% saline solution (control) or a single dose of DOM (20 mg/kg body weight (BW)) or LHRHa
(20, 50, or 80 µg/kg BW) or HCG (500, 1000, or 1500 IU/kg BW). Milt samples were collected before
hormone induction (0 h) to assess original milt properties condition, and at 24 h, 48 h, and 72 h post
injection (p.i.) to examine the effects of hormone treatments on aspects of spermiation. Results showed
that the treatment with saline solution or DOM or LHRHa did not significantly alter seminal plasma
biochemical properties.
Keywords: Waigieu seaperch, hormonal stimulation, biochemical features, LHRHa, HCG, DOM
1. ĐẶT VẤN ĐỀ
Đặc tính sinh hóa của dịch tương ở cá có
thể bị ảnh hưởng bởi nhiều yếu tố như dinh
dưỡng, các yếu tố môi trường (nhiệt độ, ánh
sáng, độ mặn), mùa vụ sinh sản, stress, di
truyền và thậm chí việc tiêm hormone kích
thích sinh sản lên cá đực (Bobe and Labbé
2010, Hajirezaee et al. 2010). Việc kích thích
58 • TRƯỜNG ĐẠI HỌC NHA TRANG
hormone cho sinh sản nhân tạo cá được dùng
phổ biến vì nó có thể làm gia tăng hoạt động
rụng trứng ở cá cái và tiết tinh ở cá đực. Tính
cho đến thời điểm này, nhiều loại hormone sẵn
có trên thị trường và được ứng dụng nghiên
cứu trên nhiều loại cá thuộc các họ trong
bộ cá vược (Perciformes) như: Cichlidae,
Percichthyidae, Moronidae, Centropomidae,
Tạp chí Khoa học - Cơng nghệ Thủy sản
Channidae,
Sparidae,
Carangidae,
Sciaenidae, Serranidae, Rachycentridae,
Scombridae, Lutjanidae. Hơn nữa, hoạt
động tiết tinh và rụng trứng của nhiều loài cá
biển kể cả họ cá chẽm (Centropomidae hay
Latidae) có thể được gia tăng do kích thích
hormone và chủ yếu là human chorionic
gonadotropin (HCG), luteinizing hormone
releasing hormone analog (LHRHa) và
domperidone (DOM) (Pham et al. 2007a,
Manós et al. 2009, Mylonas et al. 2010,
Pham et al. 2010b, Mehdi and Ehsan 2013,
Elakkanai et al. 2015, Pham and Le 2016).
Kết quả của những nghiên cứu này cho rằng
các loại hormone kích thích phù hợp với từng
lồi cá nhất định để kích thích hoạt động tiết
tinh như làm tăng các đặc tính hóa sinh của
dịch tương.
Cá chẽm mõm nhọn, Psammoperca
waigiensis (Cuvier and Valenciennes, 1828),
là một loài cá biển thuộc họ cá chẽm (Latidae
hay Centropomidae) nằm trong bộ cá vược
(Perciformes). Loài cá này được phân bố ở
vùng biển nhiệt đới thuộc châu Á Thái Bình
Dượng và châu Úc (Shimose and Tachihara
2006, Pham et al. 2012). Cùng với các loài
cá biển nhiệt đới khác đã được nuôi lâu dài
tại Việt Nam như cá mú (Epinephelus spp),
cá bớp (Rachycentron canadum), cá hồng
bạc (Lutjanus erythropterus), cá hồng Mỹ
(Scyaenops ocellatus), cá chẽm trắng (Lates
calcarifer) và cá chim vây vàng (Trachinotus
blochii). Cá chẽm mõm nhọn đã thu hút sự
chú ý như là đối tượng ni biển mới bởi
vì có giá trị kinh tế cao, ưa chuộng trên thị
trường và có khả năng thích ứng với phạm vi
rộng của các yếu tố môi trường (Nguyen et
al. 2003, Shimose and Tachihara 2006, Pham
et al. 2007a, Pham et al. 2007b, Pham et al.
2010b, Pham et al. 2012). Đây cũng là lồi
cá có thể sinh sản trong điều kiện nuôi nhốt
mà không cần kích thích hormone nhưng
kết quả sinh sản thấp (Nguyen et al. 2003).
Mùa vụ sinh sản của loài cá này diễn ra giữa
tháng 4 và tháng 10 đối với cá cái và giữa
tháng 3 và tháng 11 đối với cá đực (Pham
et al. 2012). Pham et al. (2007a) và (2010a)
báo cáo ảnh hưởng của việc sử dụng các loại
Số 4/2020
hormone khác nhau như (Thyroxin (T4),
LHRHa, carp pitutary extract (CPE), HCG or
DOM) lên một số đặc tính huyết tương của
cá chẽm mõm nhọn cái. Bên cạnh đó Le and
Brown (2016) đã nghiên cứu ảnh hưởng của
hormone lên đặc tính lý học và hình thái của
tinh trùng cá chẽm mõm nhọn. Tuy nhiên vẫn
chưa có nghiên cứu nào thực hiện để đánh giá
ảnh hưởng của hormone lên đặc tính sinh hóa
của dịch tương của lồi cá này. Vì thế, mục
tiêu của nghiên cứu này là nhằm đánh giá ảnh
hưởng của thời gian kích thích hormone với
domperidone (DOM), luteinizing hormone
releasing hormone analog (LHRHa) và human
chorionic gonadotropin (HCG) lên đặc tính
sinh hóa của dịch tương trên cá chẽm mõm
nhọn Psammoperca waigiensis sau thời gian
tiêm hormone 72h.
2. VẬT LIỆU VÀ PHƯƠNG PHÁP
NGHIÊN CỨU
2.1. Cá đực và thu tinh dịch
Cá chẽm mõm nhọn trưởng thành được
đánh bắt bằng hoạt động câu và lặn tại Vịnh
Nha Trang giữa tháng 2 đến tháng 11 năm
2012. Sau đó, cá được vận chuyển đến lồng
ni 4×4×3m đặt trong ao ni tại trại thực
nghiệm ni Hải sản Cam Ranh, Khánh Hịa.
Mặt trên của lồng được bao phủ bởi lưới bảo
vệ cá nhãy ra ngoài. Cá bố mẹ được cho ăn
hàng ngày với cá tạp được bổ sung vitamin
E với khẩu phần cho ăn là 5% khối lượng
cơ thể cá cho đến khi cá thành thục để tiến
hành thí nghiệm. Kích cỡ cá đực sử dụng
cho các thí nghiệm được trình bày ở Bảng 1.
Cá đực được gây mê bằng Ethylene glycol
monophenylether với liều lượng là 200 ppm
trước khi thu tinh dịch. Tinh dịch được thu
bằng cách ấn nhẹ nhàng bụng cá từ phía trước
ra phía sau. Tinh dịch chảy ra cho thẳng vào
ống nhựa 1.5 ml có đậy nắp. Trong q trình
thu tinh dịch, bụng cá và xung quanh lỗ huyệt
sinh dục được lau bằng khăn sạch để tránh
lẫn tạp tinh dịch với nước tiểu, phân, máu
và nhớt cá. Ồng tinh dịch sau khi thu xong
ngay lập tức bảo quản trên đá lạnh cho đến
khi sử dụng phân tích các thơng số đặc tính
hóa sinh.
TRƯỜNG ĐẠI HỌC NHA TRANG • 59
Tạp chí Khoa học - Cơng nghệ Thủy sản
Số 4/2020
Bảng 1. Khối lượng (KL, g) và chiều dài (CD, cm) của cá chẽm mõm nhọn Psammoperca
waigiensis sử dụng cho thí nghiệm
NMSL
DOM
(n=4)
(n=4)
20 (n=4)
LHRHa (µg/kg KL)
50 (n=4)
80 (n=4)
500 (n=4)
HCG (IU/kg KL)
1000 (n=4)
1500 (n=4)
KL
562,5±137,7
587,5±175,0
550,0±129,1
587,5±103,1
575,0±86,6
525,0±150,0
537,5±137,7
562,5±149,3
CD
26,8±1,4
26,9±1,7
26,8±1,4
27,0±1,1
27,0±1,1
26,5±1,6
26,5±1,4
26,6±1,4
DOM: domperidone (20 mg/kg KL); LHRHa: luteinizing hormone releasing hormone analog; HCG: and human chorionic
gonadotropin; NMSL: nước muối sinh lý 0.9%.
2.2. Thiết kế thí nghiệm
Tất cả thí nghiệm được thực hiện giữa
tháng 3 đến tháng 5 (Thời điểm cá thành thục
sinh dục) tại lồng nuôi cá bố mẹ. Tại thời điểm
bắt đầu thí nghiệm (0h), 32 con cá đực được
chọn ngẫu nhiên cho q trình thu tinh như
được mơ tả ở trên. Sau đó, 28 con cá đực được
lựa chọn ngẫu nhiên để tiêm vào gốc vây bụng
với từng loại hormone như 20 mg/kg khối
lượng (KL) domperidone (DOM) hoặc 20, 50,
80 µg/kg KL luteinizing hormone releasing
hormone analog (LHRHa) (Lam Hua Dragon
Co. Ltd., Hong Kong) hoặc 500, 1000, 1500
IU/kg KL human chorionic gonadotropin
(HCG) (Ningbo Renjian Pharmaceutical
Co.,Ltd, China). Liều lượng hormone được
sử dụng trong nghiên cứu này là dựa vào các
nghiên cứu trước trên các lồi cá biển ni
vùng nhiệt đới (Pham et al. 2007a, Manós
et al. 2009, Le and Brown 2016, Pham and
Le 2016). 04 con cá đực còn lại được tiêm
nước muối sinh lý 0,9% như là thí nghiệm đối
chứng. Cá đực sau khi tiêm xong thì mỗi con
được lưu giữ tại các lồng lưới nhỏ (1×1×3m)
riêng biệt để dễ dàng cho thao tác thu thập
tinh dịch. Cá đực sau đó được gây mê để thu
tinh dịch như mơ tả ở trên sau thời điểm 24,
48 và 72 h sau khi tiêm hormone. Đặc tính
sinh hóa của dịch tượng được xác định dựa
theo các nghiên cứu của Le et al. (2011) và Le
et al. (2014).
2.3. Phân tích đặc tính sinh hóa của dịch tương
Đặc tính hóa sinh của dịch tượng bao
gồm (ion Na, K, Ca, Mg, Cl và protein tổng
số), pH và áp suất thấm thấu. Để tiến hành
xác định các đặc tính sinh hóa này, tinh dịch
cho vào 1,5 eppendorf tube rồi sau đó li tâm
(15.000 rpm) khoảng 10 phút. Sau khi li tâm
60 • TRƯỜNG ĐẠI HỌC NHA TRANG
thì tiến hành tách phần dịch tương ở phía trên
rồi tiến hành xác định pH và áp xuất thẩm
thấu. pH được xác định bằng máy đo pH (pH
test, Romania). Nồng độ thẩm thấu được
xác định bằng máy đo áp suất thẩm thấu
(Advandced Instruments Inc., USA). Các đặc
tính hóa sinh của dịch tương được xác định
bằng máy Fuji Dri-Chem 3500 (Fujifilm Co.
Ltd., Japan).
2.4. Xử lý số liệu thống kê
Số liệu được tính tốn và trình bày dưới
dạng GTTB ± SD (độ lệch chuẩn) đối với chiều
dài và khối lượng cá thí nghiệm. Các số liệu
đặc tính hóa sinh của dịch tương được trình
bày dưới dạng GTTB ± SEM (sai số chuẩn
trung bình). Để xác định sự khác nhau đặc tính
sinh hóa của dịch tương, phương sai một yếu
tố (one-way ANOVA) và phép thử Duncan
(P<0,05) được sử dụng từ phần mềm SPSS
phiên bản 22.0.
3. KẾT QUẢ NGHIÊN CỨU VÀ THẢO
LUẬN
Kết quả ở các Bảng 2, 3, 4, 5, 6, 7, 8 và
9 cho thấy rằng: Có sự thay đổi đáng kể
nồng độ Na+, K+ (p<0,05) nhưng lại khơng
có sự thay đổi đáng kể nồng độ các ion Cl-,
Mg2+, Ca2+, protein tổng số, nồng độ thẩm
thấu cũng như pH (p>0,05) trong dịch tương
cá chẽm mõm nhọn sau khi được kích thích
bởi HCG với liều lượng 1000 IU/kg tại thời
điểm thu mẫu sau 48h và so với DOM (20
mg/kg), LHRHa (20, 50, 80 µg/kg), HCG
(500, 1000, 1500 IU/kg) và nước muối sinh
lý (đối chứng) tại các thời điểm 0h, 24h, 48h
và 72h.
Vai trò của Hormone lên sinh sản của các
loài cá xương đã được tổng hợp bởi nhiều
nghiên cứu nhằm để đảm bảo đủ lượng tinh
Tạp chí Khoa học - Cơng nghệ Thủy sản
dịch cho sinh sản nhân tạo (Manós et al.
2009, Mylonas et al. 2010, Mehdi and Ehsan
2013, Elakkanai et al. 2015). LHRHa, HCG
và DOM là một trong những loại Hormone
thường dùng để kích thích rụng trứng và
tiết tinh ở các lồi cá cái và cá đực. Hơn
nữa, sự phát triển tuyến sinh dục và sinh
sản như rụng trứng ở cá cái và tiết tinh ở cá
đực dưới sự điều khiển ba cấp độ của vùng
dưới đồi – tuyến yên – tuyến sinh dục. Bởi
vì các cơ quan này có sự tương tác với nhau
trong q trình sinh sản ở cá. Có rất nhiều
phương pháp kích thích hormone được sử
dụng trên các loại cá và tùy theo loài cá mà
loại và liều lượng hormone khác nhau (Zohar
and Mylonas 2001, Manós et al. 2009,
Mylonas et al. 2010, Pham et al. 2010b,
Zohar et al. 2010, Mehdi and Ehsan 2013,
Elakkanai et al. 2015). Một nghiên cứu của
Pham et al. (2010a) thí nghiệm tiêm HCG
Số 4/2020
1500 IU/kg BW và LHRHa 50 µg/kg BW ở
cá cái cá chẽm mõm nhọn tại thời điểm 48 h
p.i. cho kết quả nâng cao tỷ lệ đẻ nhưng lại
giảm tỷ lệ thụ tinh so với thyroxin (T4) 0.5
mg/kg. Một nghiên cứu khác gần đây của Le
and Brown (2016) cho rằng tiêm HCG 1000
IU/kg BW lên cá đực cá chẽm mõm nhọn tại
thời điểm 48 h p.i thu được thể tích tinh dịch,
tổng số tinh trùng, hoạt lực tinh trùng cũng
như thời gian hoạt lực tinh trùng cao hơn so
với các nghiệm thức thí nghiệm khác. Nghiên
cứu này cho thấy hàm lượng ion Na+ thay đổi
đáng kể ở các nghiệm thức thí nghiệm nhưng
cá ion và thành phần sinh hóa của dịch tương
thay đổi không đáng kể sau khi tiêm các loại
hormone ở các liều lượng khác nhau. Trong
khi đó báo cáo của Linhart et al. (2003) và
Verma et al. (2009) cho rằng thành phần sinh
hóa của dịch tương cá thay đổi sau khi tiêm
hormore.
Bảng 2. Nồng độ ion Na+ (mmol/l) trong dịch tương cá chẽm mõm nhọn Psammoperca
waigiensis sau khi được kích thích bởi các hormone
Kết quả được biểu diễn dưới dạng GTTB±SE. Giá trị với các ký tự khác nhau được hiểu là sai khác có ý nghĩa (chữ thường cho hàng,
chữ hoa cho cột) (ANOVA, p<0,05). TG: Thời gian; DOM: domperidone; LHRHa: luteinizing hormone releasing hormone analog; HCG:
human chorionic gonadotropin.
Bảng 3. Nồng độ ion K+ (mmol/l) trong dịch tương cá chẽm mõm nhọn Psammoperca
waigiensis sau khi được kích thích bởi các hormone
Kết quả được biểu diễn dưới dạng GTTB±SE. Giá trị với các ký tự khác nhau được hiểu là sai khác có ý nghĩa (chữ thường cho hàng,
chữ hoa cho cột) (ANOVA, p<0,05). TG: Thời gian; DOM: domperidone; LHRHa: luteinizing hormone releasing hormone analog; HCG:
human chorionic gonadotropin; NMSL: nước muối sinh lý (đối chứng).
TRƯỜNG ĐẠI HỌC NHA TRANG • 61
Tạp chí Khoa học - Cơng nghệ Thủy sản
Số 4/2020
Bảng 4. Nồng độ ion Cl- (mmol/l) trong dịch tương cá chẽm mõm nhọn Psammoperca
waigiensis sau khi được kích thích bởi các hormone
Kết quả được biểu diễn dưới dạng GTTB±SE. Giá trị với các ký tự giống nhau được hiểu là sai khác khơng có ý nghĩa (ANOVA, p>0,05).
TG: Thời gian; DOM: domperidone; LHRHa: luteinizing hormone releasing hormone analog; HCG: human chorionic gonadotropin;
NMSL: nước muối sinh lý (đối chứng).
Bảng 5. Nồng độ ion Mg2+ (mmol/l) trong dịch tương cá chẽm mõm nhọn Psammoperca
waigiensis sau khi được kích thích bởi các hormone
Kết quả được biểu diễn dưới dạng GTTB±SE. Giá trị với các ký tự giống nhau được hiểu là sai khác khơng có ý nghĩa (ANOVA, p>0,05).
TG: Thời gian; DOM: domperidone; LHRHa: luteinizing hormone releasing hormone analog; HCG: human chorionic gonadotropin;
NMSL: nước muối sinh lý (đối chứng).
Bảng 6. Nồng độ ion Ca2+ (mmol/l) trong dịch tương cá chẽm mõm nhọn Psammoperca
waigiensis sau khi được kích thích bởi các hormone
Kết quả được biểu diễn dưới dạng GTTB±SE. Giá trị với các ký tự giống nhau được hiểu là sai khác khơng có ý nghĩa (ANOVA, p>0,05).
TG: Thời gian; DOM: domperidone; LHRHa: luteinizing hormone releasing hormone analog; HCG: human chorionic gonadotropin;
NMSL: nước muối sinh lý (đối chứng).
Bảng 7. Protein tổng số (g/l) trong dịch tương cá chẽm mõm nhọn Psammoperca waigiensis
sau khi được kích bởi các hormone
Kết quả được biểu diễn dưới dạng GTTB±SE. Giá trị với các ký tự giống nhau được hiểu là sai khác khơng có ý nghĩa (ANOVA, p>0,05).
TG: Thời gian; DOM: domperidone; LHRHa: luteinizing hormone releasing hormone analog; HCG: human chorionic gonadotropin;
NMSL: nước muối sinh lý (đối chứng).
62 • TRƯỜNG ĐẠI HỌC NHA TRANG
Tạp chí Khoa học - Cơng nghệ Thủy sản
Số 4/2020
Bảng 8. Nồng độ thẩm thấu (mOsm/kg) trong dịch tương cá chẽm mõm nhọn Psammoperca
waigiensis sau khi được kích thích bởi các hormone
Kết quả được biểu diễn dưới dạng GTTB±SE. Giá trị với các ký tự giống nhau được hiểu là sai khác khơng có ý nghĩa (ANOVA, p>0,05).
TG: Thời gian; DOM: domperidone; LHRHa: luteinizing hormone releasing hormone analog; HCG: human chorionic gonadotropin;
NMSL: nước muối sinh lý (đối chứng)
Bảng 9. pH trong dịch tương cá chẽm mõm nhọn Psammoperca waigiensis sau khi được kích
thích các hormone
Kết quả được biểu diễn dưới dạng GTTB±SE. Giá trị với các ký tự giống nhau được hiểu là sai khác khơng có ý nghĩa (ANOVA, p>0,05).
TG: Thời gian; DOM: domperidone; LHRHa: luteinizing hormone releasing hormone analog; HCG: human chorionic gonadotropin;
NMSL: nước muối sinh lý (đối chứng).
Morisawa (1985) báo cáo rằng nồng độ
ion Na+ trong dịch tương cá xương nằm trong
khoảng 75 – 175 mM/l. Nồng độ ion Na+ cao
nhất trên cá chẽm mõm nhọn ở nghiên cứu này
là 151,48±1,80mM/l do được kích thích bởi
HCG 1000 IU/kg tại thời điểm thu mẫu sau
72h và thấp nhất là 138,63±1,80 mM/l do được
kích thích bởi HCG 500 IU/kg tại thời điểm thu
mẫu sau 24h, nằm trong khoảng như Morisawa
(1985) đã báo cáo; cao hơn so với nồng độ Na+
trong dịch tương cá rô 124 mM/l (Lahnsteiner
et al. 1995), cá hồi 46,21 mM/l (Bozkurt et al.
2011), tuy nhiên lại thấp hơn so với cá da trơn
164 mM/l (Tan-Fermin et al. 1999). Nồng độ
ion K+ sau khi được kích thích bởi các hormone
trong nghiên cứu này dao động trong khoảng
16,43±0,72 đến 18,28±0,26 (mM/l), tương
đương với nồng độ K+ trong dịch tương cá da
trơn 18 mM/l (Tan-Fermin et al. 1999), cao
hơn so với nồng độ K+ trong dịch tương cá rô
10 mM/l (Lahnsteiner et al. 1995), và thấp hơn
so với cá chép 70 mM/l (Morisawa et al. 1983)
và cá hồi 46 mM/l (Bozkurt et al. 2011). Sự gia
tăng đáng kể ion Na+, K+ trong nghiên cứu này
tương tự với kết luận của Linhart et al. (2003)
trong nghiên cứu trên cá Polyodon spatula rằng
việc kích thích sinh sản bằng bột tuyến yên cá
chép (Carp pituitary powder) và LHRHa dẫn
đến sự khác biệt nồng độ các ion trong dịch
tương; Seifi và ctv (2011) cũng kết luận rằng
nồng độ Na+, K+, Cl-, protein tổng số trong dịch
tương đều thay đổi đáng kể (p<0,01) bởi việc
sử dụng các hormone khác nhau (Ovaprim,
HCG, cPG) trên thí nghiệm giữa cá chép được
nuôi nhốt và cá chép được đánh bắt ngoài tự
nhiên. Tuy nhiên kết quả nghiên cứu này lại
trái ngược với kết quả nghiên cứu trên cá tầm
thìa Polyodon spatula của Linhart et al. (2003).
Nồng độ Ca2+, Mg2+ thay đổi không đáng kể
bởi việc sử dụng các hormone LHRHa (20, 50,
80 ug/kg), HCG (500, 1000, 1500 IU/kg), DOM
20 mg/kg so với tiêm nước muối sinh lý (NMSL).
Kết quả này tương tự với kết quả nghiên cứu của
Seifi et al. (2011) trên thí nghiệm giữa cá chép
được ni nhốt và cá chép được đánh bắt ngoài
tự nhiên được kích thích bởi các hormone khác
TRƯỜNG ĐẠI HỌC NHA TRANG • 63
Tạp chí Khoa học - Cơng nghệ Thủy sản
nhau (Ovaprim, HCG, cPG). Cũng giống như
vậy, các thông số dịch tương trên cá Cirrhinus
mrigala cũng được báo cáo rằng có sự ảnh
hưởng đáng kể bởi việc tiêm hormone Ovaprim
(sGnRH + Domperidon) kích thích sinh sản trên
cá đực (Verma et al. 2009).
Nồng độ thẩm thấu trong dịch tương cá
Barbus shapeyi cũng thay đổi đáng kể bởi việc
kích thích các hormone khác nhau, nồng độ
thẩm thấu cao nhất được quan sát thấy trên cá
này là do được kích thích bởi LHRHa2 (10 µg/
kg) tại thời điểm sau 16h tiêm là 320,67±2,96
(Kalbassi et al. 2014). Trong khi đó ở nghiên
cứu này, việc tiêm LHRHa không dẫn đến
nồng độ thẩm thấu cao nhất, nồng độ thẩm
thấu cao nhất trong dịch tương cá chẽm mõm
nhọn được quan sát thấy trong nghiên cứu là
344,25±4,35 do được tiêm bỏi HCG 1000 IU/
kg sau 48h (p>0,05).
pH trong dịch tương cá chẽm mõm nhọn
thay đổi không đáng kể bởi việc kích thích bằng
các hormone sinh sản so với nước muối sinh lý,
dao động trong khoảng 7,60±0,08 do được kích
thích bởi LHRHa 20 µg/kg đến 7,85±0,13 do
được kích thích bởi HCG 1000 IU/kg. pH trong
dịch tương cá bơn đuôi vàng tăng cao sau khi
được kích thích bởi GnRHa (Clearwater and
Crim 1998). Nghiên cứu của (Seifi et al. 2011)
đã báo cáo rằng pH trong dịch tương thay đổi
đáng kể (p<0,01) sau khi được kích thích bởi
hormone cPG 3 mg/kg sau 12h, HCG 1500 IU/
Số 4/2020
kg sau 12h, Ovaprim (sGnRHa+domperidon)
0,5 ml/kg sau 24h so với NMSL 0,7% ở nhóm
cá chép được ni nhốt và nhóm cá chép được
thu ngồi tự nhiên.
4. KẾT LUẬN VÀ ĐỀ XUẤT Ý KIẾN
Tóm lại, nghiên cứu ảnh hưởng của hormone
lên đặc tính sinh hóa cá chẽm mõm nhọn đực
được thể hiện thông qua thay đổi hàm lượng
ion Na+ mà khơng làm ảnh hưởng đến các
đặc tính sinh hóa khác trong dịch tương. Kết
quả nghiên cứu này cho thấy có sự ảnh hưởng
khơng đáng kể của loại, liều lượng, thời gian
sau khi tiêm các loại hormone kích thích sinh
sản lên đặc tính sinh hóa dịch tương cá chẽm
mõm nhọn đực.
Tuy nhiên, như đã thảo luận ở trên việc sử
dụng Thyroxin (T4) với liều lượng 0,5 mg/kg
thông qua chế độ ăn hoặc tiêm có kết quả tốt
hơn về tỷ lệ thụ tinh và tỷ lệ đẻ so với HCG
và LHRHA. Vì vậy cần thực hiện thêm nhiều
thí nghiệm hơn nữa với nghiệm thức sử dụng
T4 lên đặc tính sinh hóa đối với cá chẽm mõm
nhọn đực.
5. LỜI CÁM ƠN
Nghiên cứu này được tài trợ bởi Quỹ
phát triển khoa học và công nghệ quốc gia
(NAFOSTED) trong đề tài mã số 106.052017.343. Chúng tôi xin chân thành cảm ơn
đến NAFOSTED đã tài trợ kinh phí để thực
hiện nghiên cứu này.
TÀI LIỆU THAM KHẢO
1. Le, M.H., Lim, H.K., Min, B.H., Lee, J.U., Chang, Y.J., 2011. Semen properties and spermatozoan structure
of yellow croaker, Larimichthys polyactis. The Israeli Journal of Aquaculture - Bamidgeh, 1-8.
2. Pham, Q. H., Nguyen, T. A., Kjørsvik, E., Nguyen, D. M., Arukwe, A., 2012. Seasonal reproductive cycle in
Waigieu seaperch (Psammoperca waigiensis). Aquaculture Research.43, 815-830.
3. Pham, Q. H., Nguyen, T. A., Nguyen, D. M., Arukwe, A., 2010a. Sex steroid levels, oocyte maturation
and spawning performance in Waigieu seaperch (Psammoperca waigiensis) exposed to Thyroxin, Human
Chorionic Gonadotropin, Luteinizing Hormone Releasing Hormone and Carp Pituitary Extract. Comparative
and Biochemistry Physiology, Part A: Molecular & Integrative Physiology.155, 223-230.
4. Pham, Q. H., Nguyen, T. A., Nguyen, D.M., 2007a. Could Domperidone via oral administration enhance final
64 • TRƯỜNG ĐẠI HỌC NHA TRANG
Tạp chí Khoa học - Cơng nghệ Thủy sản
Số 4/2020
oocyte maturation and ovulation and in the long-term affect egg and larval quality in sand bass (Psammoperca
waigiensis)? Aquaculture Asia Vol XII No 4, October -December 2007, 35-38.
5. Pham, Q. H., Nguyen, T. A., Nguyen, D.M., 2007b. Holding salinity during the breeding season effects
final oocyte maturation and egg quality in sand bass (Psammoperca waigiensis, Cuvier & Valencienes 1828).
Aquaculture Asia Vol XII No 3, July-September 2007, 37-39.
6. Shimose, T., Tachihara, K., 2006. Age, growth and reproductive biology of the Waigieu seaperch Psammoperca
waigiensis (Perciformes: Latidae) around Okinawa Island, Japan. Ichthyology Research.53, 166-171.
7. Bobe, J., Labbé, C., 2010. Egg and sperm quality in fish. General and Comparative Endocrinology.165,
535548.
8. Bozkurt, Y., Gretmen, F., Kokcu, O., Erỗin, U., 2011. Relationships between seminal plasma composition
and sperm quality parameters of the Salmo trutta macrostigma (Dumeril, 1858) semen: with emphasis on
sperm motility. Czech J Anim Sci.56, 355-364.
9. Clearwater, S.J., Crim, L.W. , 1998. Gonadotropin releasing hormone-analogue treatment increases sperm
motility, seminal plasma pH and sperm production in yellowtail flounder Pleuronectes ferrugineus. Journal of
Fish Physiology and Biochemistry.19, 349-357.
10. Elakkanai, P., Francis, T., Ahilan, B., Jawahar, P., Padmavathy, P., Jayakumar, N., Subburaj, A., 2015. Role
of GnRH, HCG and kisspeptin on reproduction of fishes. Indian Journal of Science and Technology.8, 1-10.
11. Hajirezaee, S., Amiri, B.M., Mirvaghefi, A., 2010. Fish milt quality and major factors influencing the milt
quality parameters: A review. African Journal of Biotechnology.9, 9148-9154.
12. Kalbassi, M.R., Lorestani, R.., Marammazi, J.G., 2014. Improvement of Sperm Quality Indices of Benni
Fish (Barbus sharpeyi) by Application of LHRHA2 and Metoclopramide. J Agr Sci Tech.16, 91-104.
13. Lahnsteiner, F., Berger, B., Weismann, T., Patzner, R., 1995. Fine Structure and Motility of Spermatozoa
and Composition of the Seminal Plasma in the Perch. J Fish Biol 47, 492-508.
14. Le, M.H., Brown, Paul B., 2016. Effects of time after hormonal stimulation on milt properties in Waigieu
seaperch Psammoperca waigiensis. The Israeli Journal of Aquaculture - Bamidgeh.68, 1-10.
15. Le, M.H., Nguyen, T.H.N., Pham, P.L., 2014. Semen properties of waigieu seaperch Psammoperca
waigiensis. The Israeli Journal of Aquaculture - Bamidgeh.66, 7 pages.
16. Linhart, O., Mims, S.D., Boris Gomelsky, B., Hiott, A.E., Shelton, W.L., Cosson, J. , 2003. Ionic
composition and osmolality of paddlefish (Polyodon spathula, Acipenseriformes) seminal fluid. Aquaculture
International.11, 357-68.
17. Manós, E., Duncan, N., Mylonas, C.C. Reproduction and control of ovulation, spermiation and spawning
in cultured fish. In: Cabrita E, Robles V, Herráez MP, editors. Methods in Reproductive Aquaculture: Marine
and Freshwater Species. USA: CRC Press, Taylor & Francis Group, Boca Raton, FL, USA; 2009. p. 3-80.
18. Mehdi, Y., Ehsan, M.S., 2013. A review of the control of reproduction and hormonal manipulations in
finfish species. International Journal of Agricultural Research and Reviews.1, 15-21.
19. Morisawa, M., 1985. Initiation Mechanism of Sperm Motility at Spawning in Teleosts. Zool Sci 2, 605-615.
20. Morisawa, M., Suzuki, K., Morisawa, S., 1983. Effects of Potassium and Osmolality on Spermatozoan
Motility of Salmonid Fishes. J Exp Biol.107, 105-113.
21. Mylonas, C.C., Fostier, A., Zanuy, S., 2010. Broodstock management and hormonal manipulations of fish
reproduction. General and Comparative Endocrinology.165, 516-534.
22. Nguyen, T.N., Luc, M.D., Nguyen, D.T., 2003. Studies on artificial seed breeding of waigieu seaperch
TRƯỜNG ĐẠI HỌC NHA TRANG • 65
Tạp chí Khoa học - Cơng nghệ Thủy sản
Số 4/2020
Psammoperca waigiensis (Cuvier and Valenciennes, 1828). Components of scientific research and technological
development between the University of Fisheries and SUMA Management, Ministry of Fisheries. in Vietnamese.
23. Pham, Q.H., Kjørsvik, E., Nguyen, T.A., Nguyen, D.M., Arukwe, A., 2010b. Reproductive cycle in female
Waigieu seaperch (Psammoperca waigiensis) reared under different salinity levels and the effects of dopamine
antagonist on steroid hormone levels. Journal of Experimental Marine Biology and Ecology.383 137–145.
24. Pham, Q.H., Le, M.H., 2016. Effects of thyroxin and domperidone on oocyte maturation and spawning
performances in the rabbit fish (Siganus guttatus). Journal of the World Aquaculture Society.Accepted.
25. Seifi, T., Imanpoor, M.R., Golpour, A., 2011. The effect of different hormonal treatment on semen quality
parameters in cultured and wild carp. Turkish Journal of Fisheries and Aquatic Siences.11, 595 - 602.
26. Tan-Fermin, J.D., Miura, T., Adachi, S., Yamauchi, K., 1999. Seminal Plasma Composition, Sperm Motility
and Milt Dilution in the Asian Catfish Clarias macrocephalus (Gunther). Aquaculture.171, 323-338.
27. Verma, D.K., Routray, P., Nanda, P.K., Sarangi, N., 2009. Seasonal variation in semen: characteristics and
biochemical composition of seminal plasma of mrigal, Cirrhinus mrigala Asian Fisheries Science.22, 429-443.
28. Zohar, Y., Muñoz-Cueto, J.A., Elizur, A., Kah, O., 2010. Neuroendocrinology of reproduction in teleost
fish. General and Comparative Endocrinology.165, 438-455.
29. Zohar, Y., Mylonas, C.C., 2001. Endocrine manipulations of spawning in cultured fish: from hormones to
genes. Aquaculture.197, 99-136.
66 • TRƯỜNG ĐẠI HỌC NHA TRANG